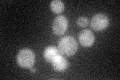
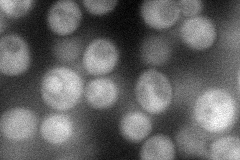
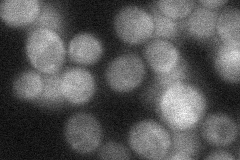
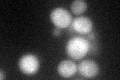

View description
Putative protein of unknown function; green fluorescent protein (GFP)-fusion protein localizes to the cytoplasm; mRNA is enriched in Scp160p-associated mRNPs; YIL161W is a non-essential gene
Localization:
Intensity:
Fold change:
Significance:
-
C’ GFP library in SD
cytosol29.39 -
N' NOP1pr-GFP in SD
cytosol52.9744 -
N' TEF2pr-mCherry in SD

cytosol45.1562 -
N' NATIVEpr-GFP in SD
cytosol35.6894 -
N' TEF2pr-VC and Cyto-VN in SD

cytosol31.9885 -
C’ GFP library in SD+DTT
cytosol30.791.04No -
C’ GFP library in SD+H2O2

cytosol250.85No -
C’ GFP library in Starvation Media

cytosol21.770.74No -
C’ GFP library on the background of Pup2-DaMP

cytosol -
C’ GFP library on the background of CCT mutant

cytosol29.18290.992672No
